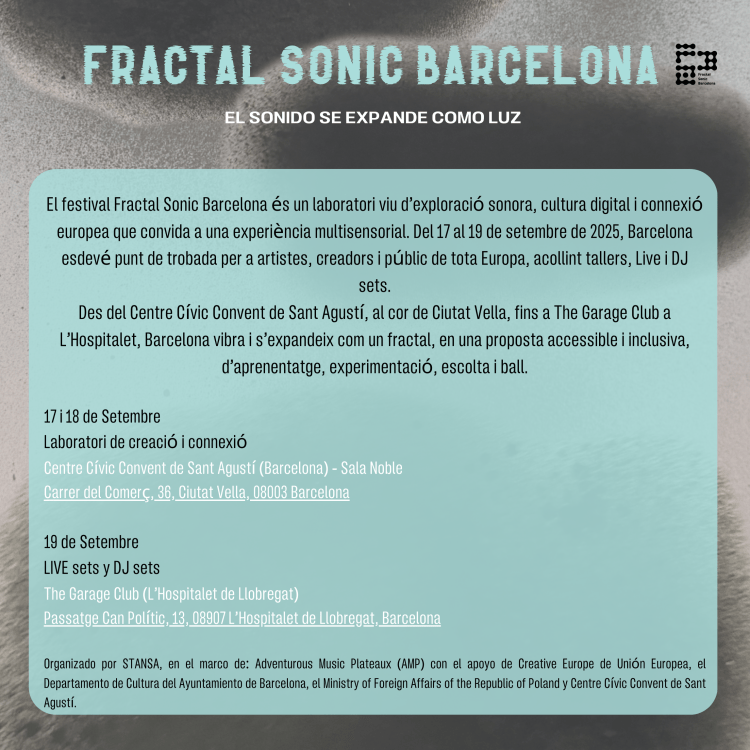

Asociación cultural y colectivo de artistas, sello musical y gestores culturales en Barcelona.
Una plataforma de difusión cultural, colaboración y encuentro

COL·LECTIU CULTURAL


NUESTRO PROYECTO
Stansa es un colectivo de artistas multidisciplinares. Una plataforma diversa especializada en la producción y promoción de música electrónica y artes visuales. Enfocado al trabajo creativo, la colaboración y el intercambio entre artistas, innovadores tecnológicos y músicos.
Stansa se estableció como un centro cultural en Barcelona en 2019 organizando eventos musicales y artísticos, ha seguido desarrollándose como un sello independiente y una plataforma artística digital que evoluciona hacia la virtualización de las artes.
Stansa is a collective of multidisciplinary artists. A diverse platform specialized on the production and promotion of electronic music and visual arts. Focused into the creative work, collaboration and exchange between artists, technological innovators and musicians. Stansa was established as a cultural center in Barcelona in 2019 curating musical and artistic events, has continued developer as an independent label and digital artistic platform evolving to arts virtualization.
STANSA ART
NFT & DIGITAL ART

Stansa NFT first release, explores the Web 3.0 into a collaborative journey though the inspiration of electronic music and digital visual arts.
Rammsy «LR Series» live composition are visualized by Joan Lavandeira into 3 digital works. Each piece, includes its digital art cover, high-quality long video and full Ep compilation.




LIGHTIN EXPERIENCE
IMMERSE EXPERIENCE – ELECTRONIC MUSIC – LIGHT INSTALLATION
STANSA RECORDS
NEW RELEASE ST04 RAMMSY – LR SERIES
RELEASE ST03 STANSA – VARIOUS ARTISTS
PODCAST: STANSA SERIES
LAST RELEASE ST02 Juan Noseke – ELLIPTIC ORBIT